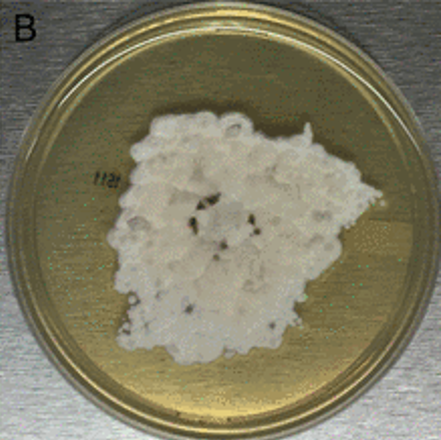

1- Histoplasma capsulatum
Exame Direto (Giemsa)

2- Histoplasma capsulatum
Aspirado MO (Giemsa + Macrófago)
3- Histoplasma capsulatum
Colônias Brancas Cotonosas

4- Histoplasma capsulatum
Tuberculate macroconidia

5- Histoplasma capsulatum
Microconídios de paredes lisas

6- Histoplasma capsulatum
Cultura Filamentosa

7- Histoplasma capsulatum
Micromorfologia Filamentosa
Pimenta do Reino Seca (enrugada)

8- Histoplasma capsulatum
Micromorfologia Filamentosa
Pimenta do Reino Seca (Enrugada)

9- Histoplasma capsulatum
Cultura Leveduriforme

10- Histoplasma capsulatum
Micromorfologia Leveduriforme
Pimenta do Reino Seca (enrugada)

11- Histoplasma capsulatum
Histopatológico (macrófagos + fungos)

12- Histoplasma capsulatum
Histopatológico (macrófagos + fungos)


